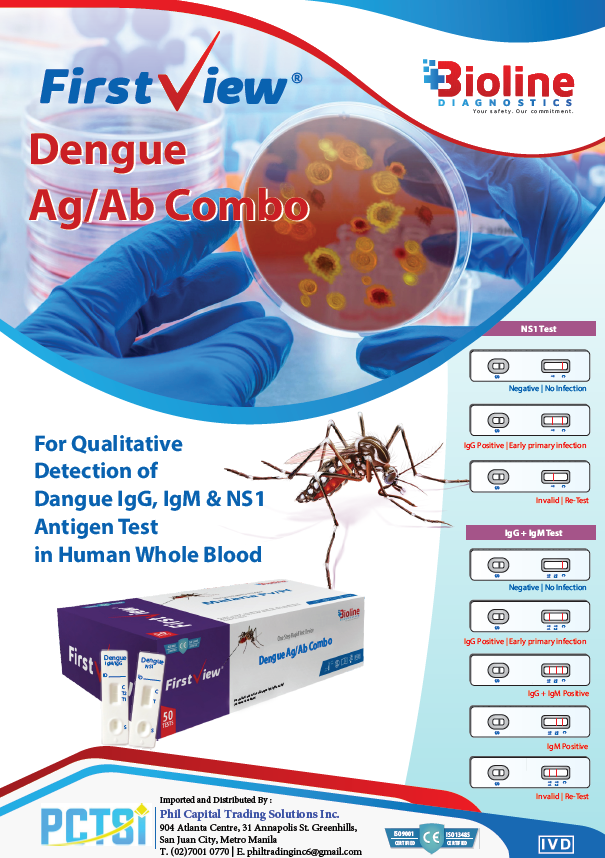

The Dengue Ag/Ab Combo & NS1 Rapid Test Kit is a one-step diagnostic device designed for the qualitative detection of Dengue NS1 antigen and IgG/IgM antibodies in human whole blood, serum, or plasma. Combining antigen and antibody testing in a single kit allows healthcare professionals to identify both early and late stages of Dengue infection quickly and accurately.
Key Features
- 3-in-1 Detection: Simultaneously detects Dengue NS1 antigen, IgM antibodies, and IgG antibodies for full infection profiling.
- Early and Late Diagnosis: NS1 antigen detection enables early diagnosis within the first few days of infection, while IgM/IgG detection identifies ongoing or past infections.
- Rapid Results: Provides clear, easy-to-read results within 15–20 minutes.
- Simple Operation: Requires no additional instruments—ideal for clinical, field, or point-of-care testing.
- High Accuracy: Combines antigen and antibody testing for improved sensitivity and specificity across all stages of infection.
- Certified Quality: Manufactured under strict ISO 13485 and ISO 9001 standards for consistent performance and reliability.
Interpretation of Results
- Negative: Only control line (C) is visible — no Dengue infection detected.
- NS1 Positive: Indicates early Dengue infection (acute phase).
- IgM Positive: Indicates a recent or primary Dengue infection.
- IgG Positive: Indicates a past or secondary Dengue infection.
- IgG + IgM Positive: Suggests an active secondary or late primary infection.
- Invalid: No control line — repeat test with a new kit.
Specifications
- Detection: Dengue NS1 antigen and Dengue IgM/IgG antibodies
- Specimen Type: Whole blood, serum, or plasma
- Testing Time: 15–20 minutes
- Storage Conditions: 2–30°C (avoid freezing)
- Operation: Qualitative lateral flow immunoassay
- Certifications: ISO 13485, ISO 9001
- Intended Use: In-vitro diagnostic use only
Download Brochure